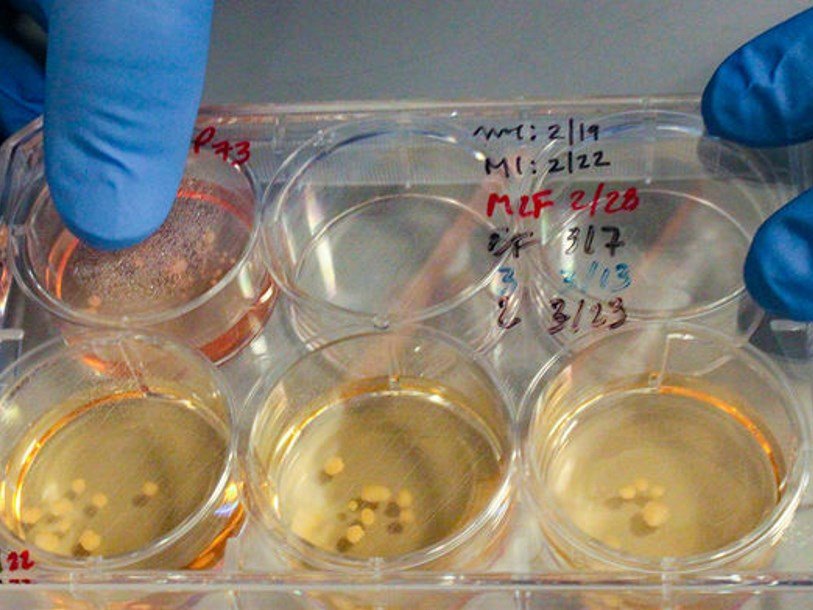

Генетики стремятся вырастить миниатюрные подобия мозга неандертальцев
Генетик Элиссон Муотри (Alysson Muotri) из Школы медицины Калифорнийского университета в Сан-Диего рассказал о ведущихся в его лаборатории экспериментов по выращиванию из клеточных культур мини-мозгов неандертальцев. Доклад об этой работе прозвучал на конференции Imagination and Human Evolution в Сан-Диего, о его содержании рассказывает сайт журнала Science. На данный момент это не попытки полного воспроизведения мозговой ткани неандертальца, клетки в эксперименте имеют лишь один неандертальский ген.
Ранее единственной возможностью узнать строение мозга неандертальцев было изучение эндокранов – отпечатков борозд и извилин головного мозга на внутренней поверхности черепа. Теперь предлагается принципиально новый метод. Он стал возможным благодаря прогрессу в трех областях: выделении древней ДНК, редактировании генома и культивировании «миниорганов». Примитивные миниатюрные аналоги настоящих органов, выращиваемые из клеточных культур, за последние годы стали значительно совершеннее. Ученые смогли получить в лабораторных условиях аналоги сердца, почки, головного мозга, желудка, легких, сетчатки, толстого и тонкого кишечника. В них есть группы дифференцированных клеток, подобные тем, что имеются в полноразмерных органах. Подробнее о таких работах мы рассказывали в очерках «Органы из пробирки» и «Миниатюрные органы».
Группа под руководством Муотри вырастила из стволовых клеток с модифицированной ДНК, которая соответствовала ДНК неандертальцев, структуры размером с горошину, которые воспроизводили ткань коры головного мозга. По сравнению с аналогичными органоидами, где содержится ДНК современных людей, “неандертальские” минимозги имеют отличия как в форме, так и в структуре нейронных сетей.
Сейчас исследования Муотри и его коллег сосредоточенны на гене NOVA1, который грает роль в раннем развитии мозга у современных людей, а также связан с аутизмом и шизофренией. Аналогичный ген неандертальца отличается от него только одной парой нуклеотидных оснований. Муотри и его сотрудники берут клетки кожи «нейротипичного человека» (то есть человека без каких-либо известных генетических дефектов, связанных с неврологическими расстройствами), затем эти клетки превращают в плюрипотентные стволовые клетки. Используя метод редактирования генома CRISPR, они вносят изменения в ген NOVA1, соответствующие геному неандертальца. За несколько месяцев из клеток вырастают кортикальные мозговые органоиды (авторы работы прозвали их неандероидами). Сравнивая их с выращенными в аналогичных условиях органоидами с обычным геномом, исследователи заметили, что нейронные клетки с неандертальским геном NOVA1 быстрее мигрируют в пределах органоида. Отличается и внешняя форма органоидов: обычные почти сферические, “неандертальские” же похожи на попкорн.
Некоторые из обнаруженных различий совпадают с признаками, которые ранее Муотри наблюдал в мозге детей с аутизмом. «Я не хочу, чтобы семьи пришли к выводу, будто бы я сравниваю аутичных детей с неандертальцами, но это важное наблюдение, – говорит Муотри. – У современных людей эти типы изменений связаны с отклонениями в развитии мозга, которые оказываются ключевыми для социализации. Если мы считаем, что это одно из наших преимуществ перед неандертальцами, это важно».